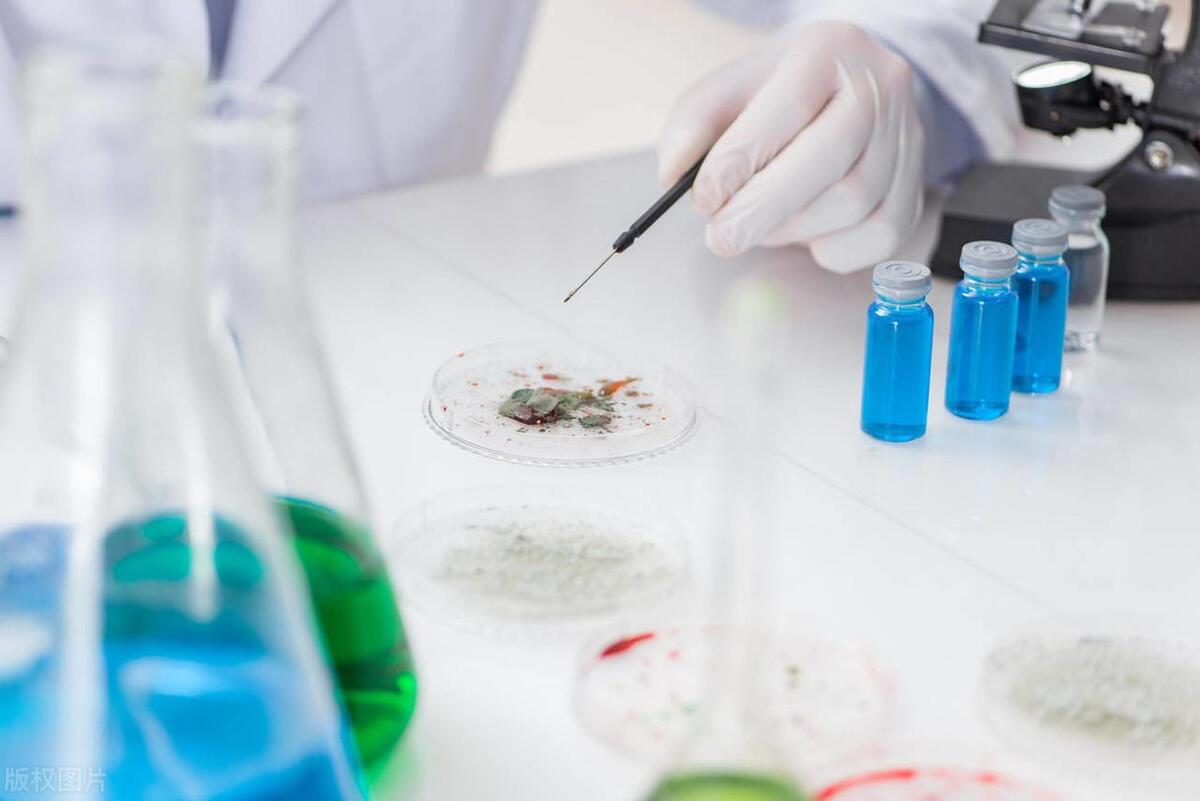
赢火虫普法|司法鉴定需要哪些材料？【干货】

本文关键字 #司法鉴定
图文来源网络,侵删
法庭上,当你和对方为了装饰装修质量唇枪舌战,对于侵权赔偿费用各执一词,因为应付工程款项争论不休……
此时此刻,法官可能会问你:“你方是否申请司法鉴定?”
究竟什么是司法鉴定?申请鉴定方又要准备好哪些材料?一起来了解一下司法鉴定的相关知识吧。

司法鉴定是什么?
司法鉴定是指在诉讼活动中鉴定人运用科学技术或者专门知识对诉讼涉及的专门性问题进行鉴别和判断并提供鉴定意见的活动。司法鉴定意见是法定证据的一种。
当事人申请鉴定的常规流程如下:

司法鉴定包括哪些类型?
司法鉴定涉及的专业种类繁多,凡是诉讼中涉及相关专门性问题的鉴定,均属司法鉴定的范围。司法鉴定可分为法医类鉴定、物证类鉴定、声像资料鉴定、环境损害鉴定及其他司法鉴定等。
·法医类鉴定
分为法医病理鉴定(例如死亡原因鉴定、死亡时间推断等)、法医临床鉴定(例如人体残疾等级鉴定、人体损伤程度鉴定等)、法医精神病鉴定(例如民事类行为能力鉴定、精神损伤类鉴定等)、法医物证鉴定(例如亲缘关系鉴定、个体识别等)及法医毒物鉴定(例如挥发性毒物鉴定、天然药毒物鉴定等)。
·物证类鉴定
分为文书鉴定(例如笔迹鉴定、印章印文鉴定等)、痕迹鉴定(例如手印鉴定、足迹鉴定等)及微量鉴定(例如食品类鉴定、化工产品类鉴定等)。
·声像资料鉴定
分为录音鉴定(例如录音真实性鉴定、录音同一性鉴定等)、图像鉴定(例如图像内容分析、图像作品相似性鉴定等)及电子数据鉴定(例如电子数据存在性鉴定、电子数据功能性鉴定等)。
·环境损害鉴定
分为污染物性质鉴定、地表水和沉积物环境损害鉴定、空气污染环境损害鉴定、土壤与地下水环境损害鉴定、近海海洋与海岸带环境损害鉴定、生态系统环境损害鉴定及其他环境损害鉴定。
·其他司法鉴定
包括但不限于产品质量鉴定、价格鉴定、知识产权鉴定、建设工程造价鉴定、建设工程质量检测鉴定、建设工程设计鉴定及会计审计等。
司法鉴定事项如何确定?
需申请方结合自身诉求/答辩、案件事实、证据等因素确定。司法鉴定内容应当尽可能明确、具体,不能概括性地提出某类司法鉴定申请(譬如申请鉴定工程质量问题),应当尽可能列明鉴定范围(譬如申请鉴定工程中3号楼和4号楼外墙部分的XX质量问题)。
申请鉴定方需要准备哪些材料?
鉴定申请书、鉴定材料清单及原件。鉴定材料原件尽可能准备齐全后递交法院,便于法院高效组织双方进行质证。
鉴定机构怎么选?
双方能协商确定的,以双方商定的有资质的鉴定机构为准。双方不能协商确定的,法院可摇号确定鉴定机构。
鉴定费用谁来付,付给谁?
鉴定费用是由申请人预交给鉴定机构的,无需支付给人民法院。费用数额以鉴定机构通知为准。鉴定费用必须依通知按时缴纳,否则可能导致鉴定程序无法启动,不利后果由申请人承担。
当事人一方主张自身工作繁忙,无法参加鉴定过程的,怎么办?
建议当事人参加鉴定过程。具体鉴定事宜(如参加时间、参加方式等)可与鉴定机构充分协商确定。
法院委托司法鉴定26问
Q1:法院对哪些情形不予委托鉴定?
A:《最高人民法院关于人民法院民事诉讼中委托鉴定审查工作若干问题的规定》(下称《委托鉴定审查规定》)第1条规定,严格审查拟鉴定事项是否属于查明案件事实的专门性问题,有下列情形之一的,人民法院不予委托鉴定:
(1)通过生活常识、经验法则可以推定的事实;
(2)与待证事实无关联的问题;
(3)对证明待证事实无意义的问题;
(4)应当由当事人举证的非专门性问题;
(5)通过法庭调查、勘验等方法可以查明的事实;
(6)对当事人责任划分的认定;
(7)法律适用问题;
(8)测谎;
(9)其他不适宜委托鉴定的情形。
《委托鉴定审查规定》第2条规定,拟鉴定事项所涉鉴定技术和方法争议较大的,应当先对其鉴定技术和方法的科学可靠性进行审查。所涉鉴定技术和方法没有科学可靠性的,不予委托鉴定。
Q2:当事人主动申请鉴定有时限要求吗?
A:根据《最高人民法院关于适用<中华人民共和国民事诉讼法>的解释》(下称《民诉法解释》)第121条规定,当事人申请鉴定,可以在举证期限届满前提出。申请鉴定的事项与待证事实无关联,或者对证明待证事实无意义的,人民法院不予准许。
根据《最高人民法院关于民事诉讼证据的若干规定》(下称《民事诉讼证据规定》)第30条规定,人民法院在审理案件过程中认为待证事实需要通过鉴定意见证明的,应当向当事人释明,并指定提出鉴定申请的期间。
符合《最高人民法院关于适用〈中华人民共和国民事诉讼法〉的解释》第九十六条第一款规定情形的,人民法院应当依职权委托鉴定。
Q3:再审申请期间,再审申请人申请法院委托鉴定的,法院是否准许?
A:根据《民诉法解释》第397条规定,审查再审申请期间,再审申请人申请法院委托鉴定、勘验的,人民法院不予准许。
Q4:当事人不主动申请鉴定,法院释明后仍不申请,但法院又认为需要鉴定的,法院可否依职权启动鉴定?
A:法院依职权启动鉴定仅限于涉及《民诉法解释》第96条规定的情形。如非该条规定情形法院不能依职权启动鉴定,而应根据举证责任分配进行处理。即当事人承担举证责任,应当申请鉴定而不申请鉴定,就应当承担不利法律后果。
Q5:如何判断鉴定人是否具有相应资质?
A:可通过“人民法院对外委托专业机构专业人员信息平台”或“人民法院委托鉴定系统”进行查询。“人民法院对外委托专业机构专业人员平台”可通过人民法院诉讼资产网进入。
Q6:鉴定程序中,法院指定或双方当事人协商确定的鉴定人可否是自然人?
A:法院在实践中主要是委托鉴定机构进行鉴定,但并不排除委托自然人进行鉴定的情况,只是委托自然人鉴定的情形较少。目前,我国逐步建立了不同领域、行业的鉴定人专家名册或专家库,比如医疗事故技术鉴定中的专家库。
Q7:鉴定期限一般多长时间?
A:《委托鉴定审查规定》第13条规定,人民法院委托鉴定应当根据鉴定事项的难易程度、鉴定材料准备情况,确定合理的鉴定期限,一般案件鉴定时限不超过30个工作日,重大、疑难、复杂案件不超过60个工作日。鉴定机构、鉴定人因特殊情况需要延长鉴定期限的,应当提出书面申请,人民法院可以根据具体情况决定是否延长鉴定期限。
Q8:当事人对鉴定书内容只要有异议就可以请求法院通知鉴定人出庭吗?
A:不能。根据《民事诉讼证据规定》第37条、第38条规定,当事人若对鉴定书的内容有异议的,法院会先要求鉴定人就异议作出解释、说明或者补充。当事人收到鉴定人的书面答复后仍有异议,且预交了鉴定人出庭费用的,法院才会通知鉴定人出庭。有异议的当事人不预交鉴定人出庭费用的,视为放弃异议。
Q9:“鉴定意见明显依据不足”主要指什么情形?
A:鉴定材料不真实、不充分或者取得方式不合法;鉴定所依据的原理、方法有问题等均属于“鉴定意见明显依据不足”。
Q10:法院准许重新鉴定情形下,鉴定机构如何确定?
A:根据《中华人民共和国民事诉讼法》第79条规定,当事人申请鉴定的,由双方当事人协商确定具备资格的鉴定人;协商不成的,由人民法院指定。当事人未申请鉴定,人民法院对专门性问题认为需要鉴定的,应当委托具备资格的鉴定人进行鉴定。《委托鉴定审查规定》第6条、第7条规定,人民法院选择鉴定机构,应当根据法律、司法解释等规定,审查鉴定机构的资质、执业范围等事项。当事人协商一致选择鉴定机构的,人民法院应当审查协商选择的鉴定机构是否具备鉴定资质及符合法律、司法解释等规定。发现双方当事人的选择有可能损害国家利益、集体利益或第三方利益的,应当终止协商选择程序,采用随机方式选择。
需特别注意的是,《民事诉讼证据规定》第40条规定,重新鉴定的,原鉴定意见不得作为认定案件事实的根据。
Q11:鉴定意见出具后,什么情形下需要进行补充鉴定?
A:按照《民事诉讼证据规定》和《委托鉴定审查规定》的相关规定进行审查判断。《民事诉讼证据规定》第40条规定,对鉴定意见的瑕疵,可以通过补正、补充鉴定或者补充质证、重新质证等方法解决的,人民法院不予准许重新鉴定的申请。
Q12:当事人能自行委托鉴定吗?
A:《民事诉讼证据规定》第四十一条规定,对于一方当事人就专门性问题自行委托有关机构或者人员出具的意见,另一方当事人有证据或者理由足以反驳并申请鉴定的,人民法院应予准许。由该规定可知,当事人可就专门性问题自行委托有关机构或者人员出具的意见,当事人自行委托机构出具的意见属于单方提交的证据。
Q13:行政主管部门对专门性问题进行认定过程中所作的鉴定报告(交警队交通事故责任认定书、医学会医疗事故等级鉴定、火灾事故认定等)是否属于鉴定意见?
A:这类行政主管部门出具的鉴定报告属于书证,如果是国家机关等公共管理机关在行使公权力的过程中基于权限所制作的文书则是公文书,该公文书作为证据使用时即为公文书证。
Q14:鉴定所需资料由另一方持有且拒不提供,导致无法鉴定,该责任由谁承担?
A:因控制鉴定材料的一方当事人拒不提供鉴定材料导致鉴定不能,该不利结果应由控制书证的一方当事人承担。《江苏省高级人民法院建设工程施工合同纠纷案件司法鉴定操作规程》第十一条和第十二条涉及该问题的处理方式,可作为参考。该《规程》第十一条规定,当事人应当在人民法院指定的时间内提交鉴定资料,控制鉴定资料的一方当事人逾期不提供导致相关争议项无法确定的,人民法院可以根据案件审理情况认定对方当事人主张的相关事实成立。《规程》第十二条规定,控制鉴定资料的一方当事人经释明后拒不提供资料,导致鉴定无法进行的,人民法院可以终结鉴定,由拒不提供资料的一方当事人承担相应不利后果;双方均有能力提供,经释明后均未提供的,由对相关争议事实承担举证责任的一方当事人承担相应不利后果。
Q15:有专门知识的人出庭,属于什么证据种类?
A:有专门知识的人只能就鉴定意见发表质证意见或就专业问题发表意见,属于辅助诉讼角色。不属于法定证据种类。
Q16:当事人可以口头方式申请具有专门知识的人出庭吗?
A:不可以。此种申请只能以书面方式提出,口头申请并不发生申请的效果,未提交申请书的,视为未提出申请。如果当事人在法院询问、开庭审理过程中以口头方式当场提出的,其申请时间应当以其提交申请书时确定。由于当事人的申请行为可以视为举证行为,当事人提交申请书时间在举证期限届满后的,则产生逾期举证的后果。
Q17:有专门知识的人参与诉讼活动的范围是什么?
A:有专门知识的人在庭审中仅能对鉴定意见质证或者就专业问题发表意见,除此之外,不得参与其他庭审活动。
Q18:什么是视听资料的原始载体?
A:视听资料储存在模拟信号中,它的载体一般呈现为录影带、录像带、录音带等。
Q19:哪些可视为电子数据的原件?
A:电子数据的制作者制作的与原件一致的副本,或者直接来源于电子数据的打印件或其他可以显示、识别的输出介质,视为电子数据的原件。如最始生成、存储数据的电脑硬盘就是电子数据原件,该数据复制到移动U盘上(与原件一致),或打印成可读物,该U盘、可读物即可视为电子数据的原件。但又恰因电子数据易被删改,所以视为原件的证据与原件证据是否一致,是否直接来源于原件的识别就非常重要。
Q20:主要从哪些方面判断电子副本可视为电子数据原件?
A:可以从电子副本是否可准确反映原始数据内容的输出物或显示物;是否具有最终完整性和可供随时调取查用;双方当事人是否对其提出原始性异议;是否经公证机关有效公证、不利方当事人能否提供反证*翻推**;是否附加可靠电子签名或其他安全程序保障;是否满足法律另行规定或当事人专门约定的其他标准等角度判断。
Q21:手机(电子介质)录音、录像属于视听资料还是电子数据证据?
A:“视听资料,是指借助录音、录像、电子计算机设备等技术手段所记载和再现的声音、图像、数据等信息资料”“当电子数据这些数字、编码依靠电子信息设备外化成具有思想内容的、直观的、可视可听的声音和影像时,就形成了视听资料”,如上,音、像资料均属于视听资料。但根据《民诉法解释》第116条规定,存储在电子介质中的录音资料和影像资料,适用于电子数据的规定。由此可见,从证据种类而言,存储在模拟信号介质中的音、像资料归属于视听资料证据,而存储在电子介质中的音、像资料归属于电子数据证据,而非仅仅适用于电子数据规则。据此,手机(电子介质)录音、录像应归属于电子数据证据。
Q22:如何判断电子数据真实性?
A:人民法院对于电子数据的真实性,应当结合下列因素综合判断:
(一)电子数据的生成、存储、传输所依赖的计算机系统的硬件、软件环境是否完整、可靠;
(二)电子数据的生成、存储、传输所依赖的计算机系统的硬件、软件环境是否处于正常运行状态,或者不处于正常运行状态时对电子数据的生成、存储、传输是否有影响;
(三)电子数据的生成、存储、传输所依赖的计算机系统的硬件、软件环境是否具备有效的防止出错的监测、核查手段;
(四)电子数据是否被完整地保存、传输、提取,保存、传输、提取的方法是否可靠;
(五)电子数据是否在正常的往来活动中形成和存储;
(六)保存、传输、提取电子数据的主体是否适当;
(七)影响电子数据完整性和可靠性的其他因素。
人民法院认为有必要的,可以通过鉴定或者勘验等方法,审查判断电子数据的真实性。可及时申请鉴定或勘验,以此解决电子数据真实性问题。
Q23:人民法院可以确认电子数据真实性的情形有哪些?
A:电子数据存在下列情形的,人民法院可以确认其真实性,但有足以反驳的相反证据的除外:
(一)由当事人提交或者保管的于己不利的电子数据;
(二)由记录和保存电子数据的中立第三方平台提供或者确认的;
(三)在正常业务活动中形成的;
(四)以档案管理方式保管的;
(五)以当事人约定的方式保存、传输、提取的。
电子数据的内容经公证机关公证的,人民法院应当确认其真实性,但有相反证据足以*翻推**的除外。
Q24:电子数据由记录和保存的中立第三方平台提供或者确认的,法院可以确认真实性。这里的中立第三方平台有哪些?
A:如网络购物中的淘宝、京东等第三方平台,收发电子邮件的服务提供商,电子支付的银行系统。
Q25:电子数据在正常业务活动中形成的,法院可以确认真实性。正常业务活动中形成的电子数据指哪些?
A:各民事主体在日常业务活动中按照行业惯例、业务习惯形成的电子数据,如银行在营业厅拍摄的监控录像;银行综合核算系统产生的流水账表、交易明细等每日交易记录;交通管理部门安装的检测器录制的违章记录;电子商务企业在日常运营中制作的电子账簿、电子发票等。
Q26:电子数据以档案管理方式保管的,法院可以确认真实性。以档案管理方式保管的电子数据指哪些?
A:例如电子数据《企业信用信息公示报告》,该证据系从国家企业信息公示系统上查询所得,该信息与从企业注册地登记机关调取的档案机读材料具有同源性,应与传统档案机读材料具有相同的证据效力。